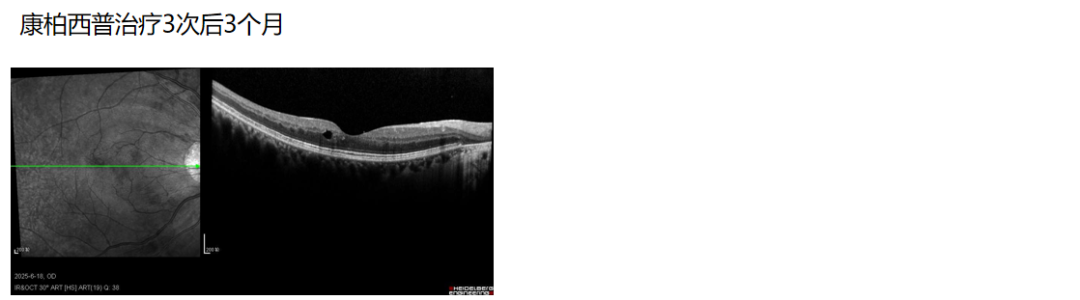
1761129261358589.png 1761129261358589.png

编者按:“眼底病规范化诊疗实践——大咖话规范”栏目自启动以来广受眼科医师们的欢迎,众多眼科医师纷纷投稿,分享了规范化诊疗学习与实施后的案例,栏目有效促进了规范化诊疗的持续学习与落地实践。现将精选案例在”中华眼底病杂志“公众号进行展播。
视网膜中央静脉阻塞(CRVO)是临床常见的视网膜血管疾病,其引发的黄斑水肿(ME)是导致患者视力急剧下降甚至丧失的主要原因,严重影响患者日常生活与工作能力。当前,抗血管内皮生长因子(VEGF)药物治疗通过抑制异常血管通透性,从而促进ME的消退,已成为视网膜静脉阻塞伴ME(RVO-ME)治疗的一线核心方案。在本期病例展播中,将由来自福建医科大学附属协和医院王冰医生、江南大学附属医院王春芳医生以及宜兴市中医医院李萍医生提供的三个CRVO规范诊疗的临床病例,为大家的工作带来启迪。

福建医科大学附属协和医院
王冰医生病例分享
病例介绍
患者女性,75岁,因“左眼渐进性视物模糊1年余”就诊。现病史:患者1年余前无明显诱因出现左眼视物模糊,无眼红、眼痛、恶心、呕吐,无虹视、复视,无眼外伤史。曾在外院使用雷珠单抗治疗3针,视力无明显改善,为进一步诊治来院。既往史: 否认糖尿病、高血压病史。眼部检查:视力:右眼0.6,左眼数指(FC)/20 cm。双眼眼压正常;双眼结膜无充血,角膜透明,前房中深;双眼晶状体轻度混浊,玻璃体散在混浊;右眼眼底未见明显异常,左眼眼底模糊见血管纡曲及散在“火焰状”出血。辅助检查:

双眼眼底彩色照相:右眼视盘周围可见萎缩灶,其余未见明显异常;左眼可见视网膜“火焰状”、深浅不一的出血,静脉纡曲扩张

双眼荧光素眼底血管造影(FFA):右眼造影过程未见明显异常荧光。左眼视网膜静脉纡曲扩张,管壁荧光染色轻微渗漏;中周部视网膜散在小片状出血遮蔽荧光,周边部视网膜大片无灌注区;黄斑颞侧片状无灌注区,黄斑周围毛细血管荧光素渗漏,晚期黄斑中心“花瓣样”荧光积存

双眼光相干断层扫描(OCT):右眼黄斑区未见明显异常;左眼黄斑区神经上皮层增厚,层间结构不清,中心凹形态改变,局部见囊样无反射,外层结构反射缺失
治疗方案及患者转归
根据患者病史、症状、眼部体征及辅助检查,诊断为左眼CRVO-ME、双眼白内障。考虑到患者此前使用雷珠单抗3针后疗效不佳,临床团队评估后,将治疗方案转换为康柏西普玻璃体腔注射[3+按需治疗(PRN)方案] 联合全视网膜激光光凝(PRP)治疗。改为康柏西普治疗1次后,1个月复查左眼视力由FC/50 cm提升至0.05(约20个字母),中央视网膜厚度(CRT)由707 μm降低至612 μm。康柏西普治疗2次后CRT进一步降低至212 μm。换用康柏西普治疗10个月后,视力维持在0.12,CRT保持在195 μm。
图:左眼进行康柏西普转换治疗前后的眼底彩色照相

图:左眼进行康柏西普转换后的FFA:左眼视网膜静脉纡曲扩张管壁荧光染色渗漏减轻;中周部视网膜散在小片状出血遮蔽荧光,周边部视网膜散在激光斑;黄斑颞侧片状无灌注区减少,黄斑周围毛细血管荧光素渗漏,晚期黄斑中心“花瓣样”荧光积存

图:左眼进行康柏西普转换治疗前后的OCT
病例小结
该病例为老年女性缺血型CRVO-ME患者,病程长达1年余,且前期使用雷珠单抗治疗应答不佳,属于临床治疗难度较高的类型。新生血管是RVO的远期并发症之一,会导致虹膜新生血管、青光眼、玻璃体积血等系列新生血管并发症,及早抗VEGF药物治疗,可以降低新生血管生成的风险,避免这些并发症发生。
相较于单抗类药物,多靶点作用的融合蛋白康柏西普有强效保护视网膜神经血管单元(NVU)的优势,尤其对于病程较久、缺血明显的RVO-ME患者,需要更强有力的保护,一旦发现单抗类药物应答不佳,应尽早转换。康柏西普的强效抗炎与血管保护作用可更好地控制病情进展。其在治疗CRVO所致ME中起效快速,且视力维持长达10个月的稳定,规范注射康柏西普在CRT下降方面表现得更加显著,显示了其在快速消退水肿和长期维持视力稳定方面的优势。
同时,定期随访中需密切关注无灌注区变化,一旦发现明确无灌注区,应及时联合PRP治疗,为患者长期视力稳定提供保障。

江南大学附属医院
王春芳医生病例分享
病例介绍
患者男性,44岁,因“右眼突发视物模糊2 d”就诊。现病史:患者2 d前无明显诱因出现右眼视物模糊,无眼红、眼痛、畏光、流泪,无视物变形、重影,未进行特殊处理,症状无改善,为明确诊治来院。既往史:否认糖尿病、高血压、高血脂等慢性病史。眼部检查:视力:右眼0.5,左眼1.0。双眼眼压正常;双眼晶状体透明,玻璃体透明;左眼眼底未见明显异常;右眼视盘水肿、充血,静脉纡曲,动脉变细,围绕视盘周围见反射状出血,ME,黄斑反光点未见,视网膜平伏。辅助检查:

右眼眼底彩色照相:右眼视盘充血水肿,黄斑部轻度水肿,静脉高度纡曲扩张,可见视网膜沿静脉散在“火焰状”出血

右眼FFA:13 s动脉开始充盈,18 s静脉开始充盈,33 s充盈完全;静脉纡曲扩张,管壁轻度着染,后期视盘可见荧光素渗漏,黄斑区可见少许“蜂窝状”荧光积存

右眼OCT:后极部神经上皮层弥漫增厚水肿,不规则遮蔽下方组织反射;黄斑中心凹下方可见外核层液性暗腔囊样水肿
治疗方案及患者转归
根据患者病史、症状、眼部体征及辅助检查,诊断为右眼CRVO、屈光不正。完善生化常规、凝血常规、传染病检测、自身免疫性抗体检测、ANCA抗体检测、抗磷脂抗体检测、血半胱胺酸检测、心脏彩色超声、颈动脉彩色超声检查等均未见明显异。考虑到FFA显示静脉管壁荧光着染,提示存在静脉炎症,给予右眼康柏西普玻璃体腔注射治疗(3+PRN方案),联合全身口服小剂量糖皮质激素辅助抗炎治疗。康柏西普治疗1次后,右眼视力即提升至1.0,ME消退,CRT从治疗前的549 μm降低至228 μm。连续3次治疗后25 d,视力维持在1.0,ME无复发,CRT 227 μm,连续3次治疗后3个月,仅黄斑区颞侧外核层见小囊泡改变,补充注射1针后1周,囊泡消失,视力维持在1.0。

图:右眼进行康柏西普治疗前后的眼底彩色照相
图:右眼进行康柏西普治疗前三次后25 d的FFA
图:右眼进行康柏西普治疗前后的OCT
病例小结
该患者为青年男性,无慢性基础疾病,右眼CRVO-ME,提示RVO发病并非老年人群所特有,青年患者也需警惕。本例患者采用康柏西普抗VEGF药物治疗联合小剂量糖皮质激素,充分发挥康柏西普三靶点(VEGF-A/B、胎盘生长因子)、强效抗炎、全面保护视网膜NVU的优势,实现了快速起效:1针后2 d视力即提升至0.6,1个月提升至1.0,3针治疗后3个月视力仍维持1.0;CRT显著下降,1针消退水肿且中期随访3个月仍保持稳定。
本例证实,对于CRVO-ME患者,早期足量规范化抗VEGF药物治疗(如3+PRN方案)可快速控制病情、改善视力,减少疾病对患者工作与生活的影响。同时,需重视病因排查,本例患者完善生化常规、凝血常规、自身免疫抗体检测、心脏及颈动脉彩色超声等检查均未见异常,排除了常见危险因素,为后续随访与管理提供了明确方向。

宜兴市中医医院
李萍医生病例分享
病例介绍
患者男性,76岁,因“左眼突发视力下降1周”就诊。现病史:患者1周前无明显诱因出现左眼视物模糊,伴眼前黑影遮挡、视物变形,遂来院就诊。既往史:有高血压、冠心病、颈动脉斑块病史。眼部检查:视力:右眼0.8,左眼0.06。双眼眼压:右眼9.0 mmHg,左眼7.0 mmHg。双眼晶状体轻度混浊,玻璃体轻度混浊;右眼眼底未见明显异常,左眼视网膜静脉纡曲,全视网膜各象限广泛片状出血,视盘水肿,伴ME。
辅助检查:

左眼眼底彩色照相:视盘水肿,视网膜静脉纡曲扩张,全视网膜各象限广泛片状出血,视盘周围见棉绒斑

左眼OCT:黄斑区视网膜内强反射物质,黄斑囊样水肿,伴视网膜下液(SRF),CRT 861 μm
治疗方案及患者转归
根据患者病史、症状、眼部体征及辅助检查,诊断为左眼CRVO、双眼白内障、双眼玻璃体混浊。给予左眼康柏西普玻璃体腔注射治疗,初始采用3+PRN治疗方案(前6针),患者随访病情稳定后,后续调整为治疗-延长(T&E)方案。康柏西普治疗1次后,视力即由0.06提升至0.3,CRT由861 μm显著下降至444 μm。连续3次治疗后,视网膜内强反射物质基本消退,SRF完全吸收,CRT 256 μm。治疗后长期随访20个月结果显示,患者视力与CRT持续改善并保持稳定。左眼视力从治疗前0.06逐步提升,20个月时达到0.6;CRT从治疗前861 μm逐步下降,20个月时稳定在266 μm。

图:左眼进行康柏西普治疗前后的眼底彩色照相(康柏西普连续3次治疗后,左眼玻璃体混浊减轻,视盘水肿减轻,视网膜出血及棉绒斑明显吸收减少;维持期治疗至20周时,眼底出血完全吸收)


图:左眼进行康柏西普治疗前后的OCT:康柏西普治疗1次后1个月,CRT较基线降低417 μm;连续3次治疗后,视网膜内强反射物质基本消退,SRF完全吸收(CRT 256 μm);第20个月复诊,CRT289 μm,予以第9次治疗(治疗后CRT266 μm)
病例小结
该病例为老年男性患者,合并多种心血管基础疾病,左眼CRVO-ME病情严重,初始视力仅0.06,CRT高达861 μm。临床团队采用康柏西普抗治疗,结合病情动态调整方案(从3+PRN转为T&E),实现了快速起效、长期稳定的治疗效果:不仅短期内快速消退水肿、提升视力,长期随访20个月期间,视力持续改善至0.6,CRT稳定在正常范围,且未出现严重并发症,早期足量足疗程规范化治疗可以给患者带来更好的获益。
治疗过程中,需特别注意CRVO-ME易复发的特点,本例患者在连续3次治疗后,ME曾于注射后2-3个月反复发作,及时调整为T&E方案后,有效维持了视力与解剖学稳定,延长了治疗间隔,减轻了患者治疗负担。RVO水肿易反复,对患者进行科学患者宣教、对患者进行长期规范化随访和治疗管理,根据患者随访结果及时予以维持治疗或调整治疗方案,对患者的预后及减轻患者治疗负担有重要的意义。
声明:本文仅供医疗卫生专业人士学术交流,不代表本平台观点。该等信息不能以任何方式取代专业的医疗指导,也不应被视为诊疗建议,如果该信息用于资讯以外的目的,本平台及作者不承担相关责任。